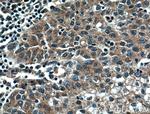
DNAJC2/MPP11 Antibody in Immunohistochemistry (Paraffin) (IHC (P))

Search
Proteintech
DNAJC2/MPP11 Polyclonal Antibody
{{$productOrderCtrl.translations['antibody.pdp.commerceCard.promotion.promotions']}}
{{$productOrderCtrl.translations['antibody.pdp.commerceCard.promotion.viewpromo']}}
{{$productOrderCtrl.translations['antibody.pdp.commerceCard.promotion.promocode']}}: {{promo.promoCode}} {{promo.promoTitle}} {{promo.promoDescription}}. {{$productOrderCtrl.translations['antibody.pdp.commerceCard.promotion.learnmore']}}
产品信息
11971-1-AP
种属反应
宿主/亚型
分类
类型
抗原
偶联物
形式
浓度
规格
纯化类型
保存液
内含物
保存条件
运输条件
产品详细信息
Immunogen sequence: MLLLPSAAD GRGTAITHAL TSASTLCQVE PVGRWFEAFV KRRNRNASAS FQELEDKKEL SEESEDEELQ LEEFPMLKTL DPKDWKNQDH YAVLGLGHVR YKATQRQIKA AHKAMVLKHH PDKRKAAGEP IKEGDNDYFT CITKGSPGDS YQKLILQLIH LMKCYLIQ (1-167 aa encoded by BC056682)
靶标信息
EIF4EBP1 is one member of a family of translation repressor proteins. It directly interacts with eukaryotic translation initiation factor 4E (eIF4E), which is a limiting component of the multisubunit complex that recruits 40S ribosomal subunits to the 5' end of mRNAs. Interaction of this protein with eIF4E inhibits complex assembly and represses translation. This protein is phosphorylated in response to various signals including UV irradiation and insulin signaling, resulting in its dissociation from eIF4E and activation of mRNA translation.
仅用于科研。不用于诊断过程。未经明确授权不得转售。
生物信息学
蛋白别名: (rat homolog) mouse id-associated protein 1; DnaJ (Hsp40) homolog, subfamily C, member 2; DnaJ homolog subfamily C member 2; Gliosarcoma-related antigen MIDA1; Id associate 1; M-phase phosphoprotein 11; MIDA1; Mouse Id associate 1; zuotin related factor 1; zuotin related factor 2; Zuotin-related factor 1
基因别名: AU020218; DNAJC2; MIDA1; MPHOSPH11; MPP11; ZRF1; Zrf2; ZUO1
UniProt ID: (Human) Q99543, (Rat) Q7TQ20, (Mouse) P54103
Entrez Gene ID: (Human) 27000, (Rat) 116456, (Mouse) 22791